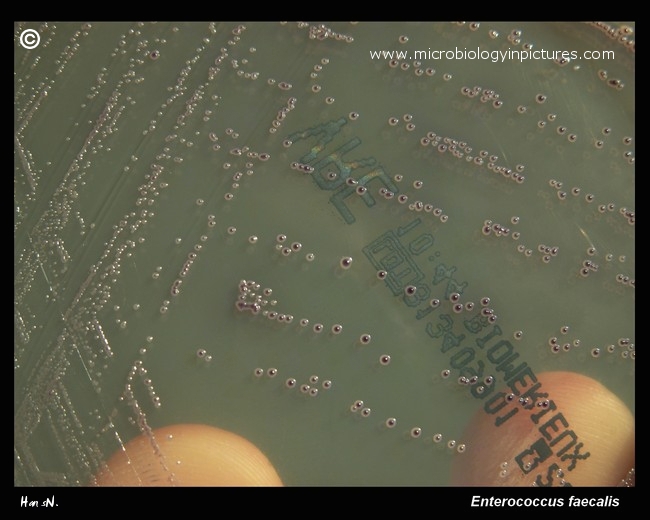
colonies of Enterococcus faecalis, VRE bacteria

Colonies of vancomycin resistant Enterococcus faecalis (VRE) on a diagnostic-selective medium for VRE. Vancomycin resistant
enterococci agar is formulated as per the recommendations of Centre for Disease Control and Prevention (CDC) for the
selective isolation of vancomycin resistant enterococci. Vancomycin supplement helps in the selective isolation of vancomycin resistant
enterococci from other enterocci. Meropenem supplement added to the medium helps to suppress the contaminating
flora especially gram-negative bacteria. Cultivated 24 hours, 37°C.
